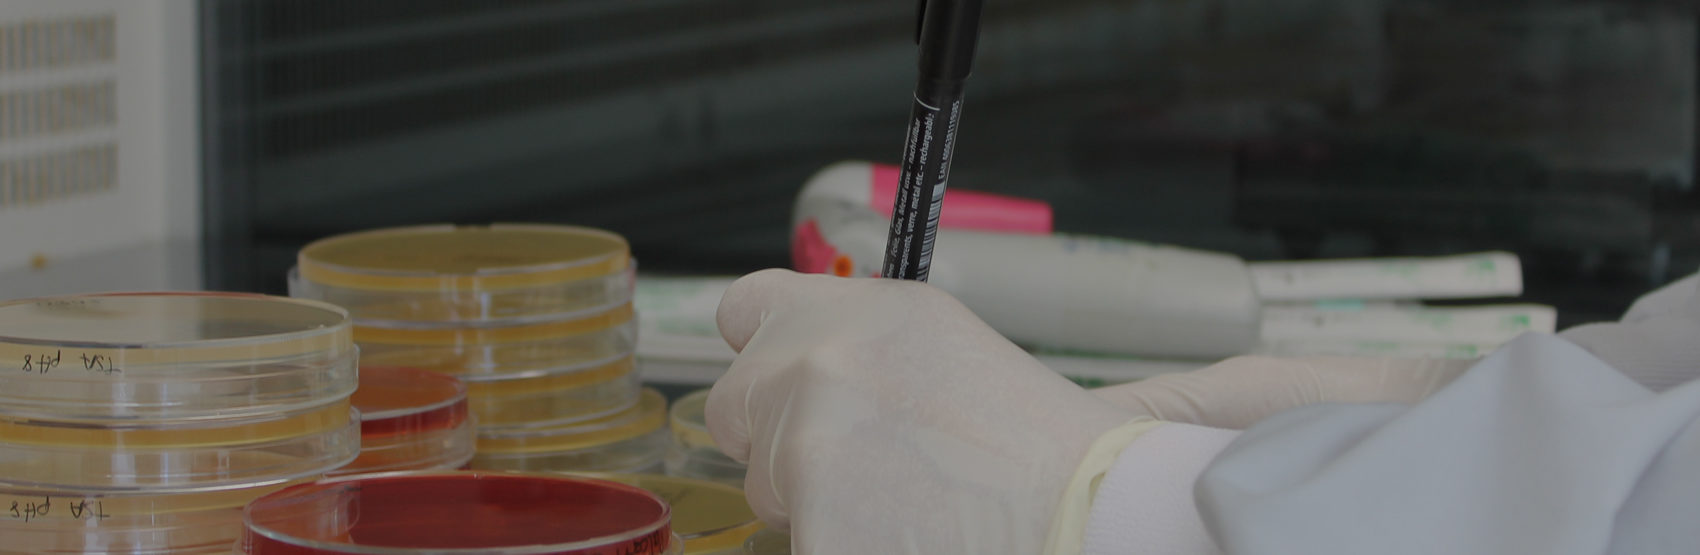

Suscríbete a nuestra newsletter
- Líneas I+D+i
- Servicios Tecnológicos
- Servicios Consultoría
- Servicios Laboratorio
- Formación y Eventos
- Sectores
AINIA investigará y desarrollará nuevos ingredientes bioactivos con actividad antimicrobiana frente a patógenos que aparecen en la cadena de producción de alimentos, y cuyo origen está asociado a los animales criados para la obtención de alimentos o productos de origen animal.
El proyecto Microbiosafe, que ahora inicia AINIA, pretende aplicar estos compuestos de forma multisectorial ya que pueden ser incorporados a alimentos como sistemas de conservación; a aditivos en alimentación animal para reducir la utilización de antibióticos en sistemas de producción animal, así como en productos de limpieza industrial para eliminar su presencia en toda la cadena del procesado de los alimentos.
“La aparición de cepas de patógenos resistentes a los antibióticos tradicionales hace cada vez más necesario innovar en estrategias antimicrobianas más selectivas, que no generen problemas de resistencia. Entre las estrategias a evaluar en el marco del proyecto se encuentran los péptidos antimicrobianos (bacteriocinas), el uso de virus bacteriófagos o enzimas producidas por éstos (endolisina)”, ha señalado Ana Torrejón, del departamento de Biotecnología Industrial de AINIA.
Las endolisinas son unas enzimas producidas por los virus bacteriófagos, con secuencias específicas para cada uno de ellos, que les permiten actuar frente a una determinada especie o grupo de especies de bacterias.
Según ha explicado Ana Torrejón, “este tipo de enzimas resulta muy interesante de cara al tratamiento de patógenos bacterianos. Por este motivo, las endolisinas tienen un gran potencial como sustitutas de antibióticos o como complemento otros tipos de antimicrobianos”
El proyecto MICROBIOSAFE, apoyado por el Instituto Valenciano para la Competitividad Empresarial (IVACE) y fondos FEDER se enmarca en los proyectos de I+D+i que lleva a cabo AINIA para garantizar la seguridad alimentaria.

Eva Sánchez
Contribuyo a dar visibilidad al conocimiento generado en proyectos de I+D+i, creando estrategias y contenidos que acercan la innovación tecnológica a la sociedad. Mi trabajo consiste en diseñar e implementar estrategias de comunicación que impulsan la visibilidad de iniciativas innovadoras, transmitiendo de forma rigurosa el valor de la investigación y la tecnología.


| Responsable | AINIA |
| Domicilio | Calle Benjamín Franklin, 5 a 11, CP 46980 Paterna (Valencia) |
| Finalidad | Atender, registrar y contactarle para resolver la solicitud que nos realice mediante este formulario de contacto |
| Legitimación | Sus datos serán tratados solo con su consentimiento, al marcar la casilla mostrada en este formulario |
| Destinatarios | Sus datos no serán cedidos a terceros |
| Derechos | Tiene derecho a solicitarnos acceder a sus datos, corregirlos o eliminarlos, también puede solicitarnos limitar su tratamiento, oponerse a ello y a la portabilidad de sus datos, dirigiéndose a nuestra dirección postal o a privacy@ainia.es |
| Más info | Dispone de más información en nuestra Política de Privacidad |
| DPD | Si tiene dudas sobre como trataremos sus datos o quiere trasladar alguna sugerencia o queja, contacte al Delegado de protección de datos en info@businessadapter.es o en el Formulario de atención al interesado |
Consiento el uso de mis datos personales para que atiendan mi solicitud, según lo establecido en su Política de Privacidad
Consiento el uso de mis datos para recibir información y comunicaciones comerciales de su entidad.